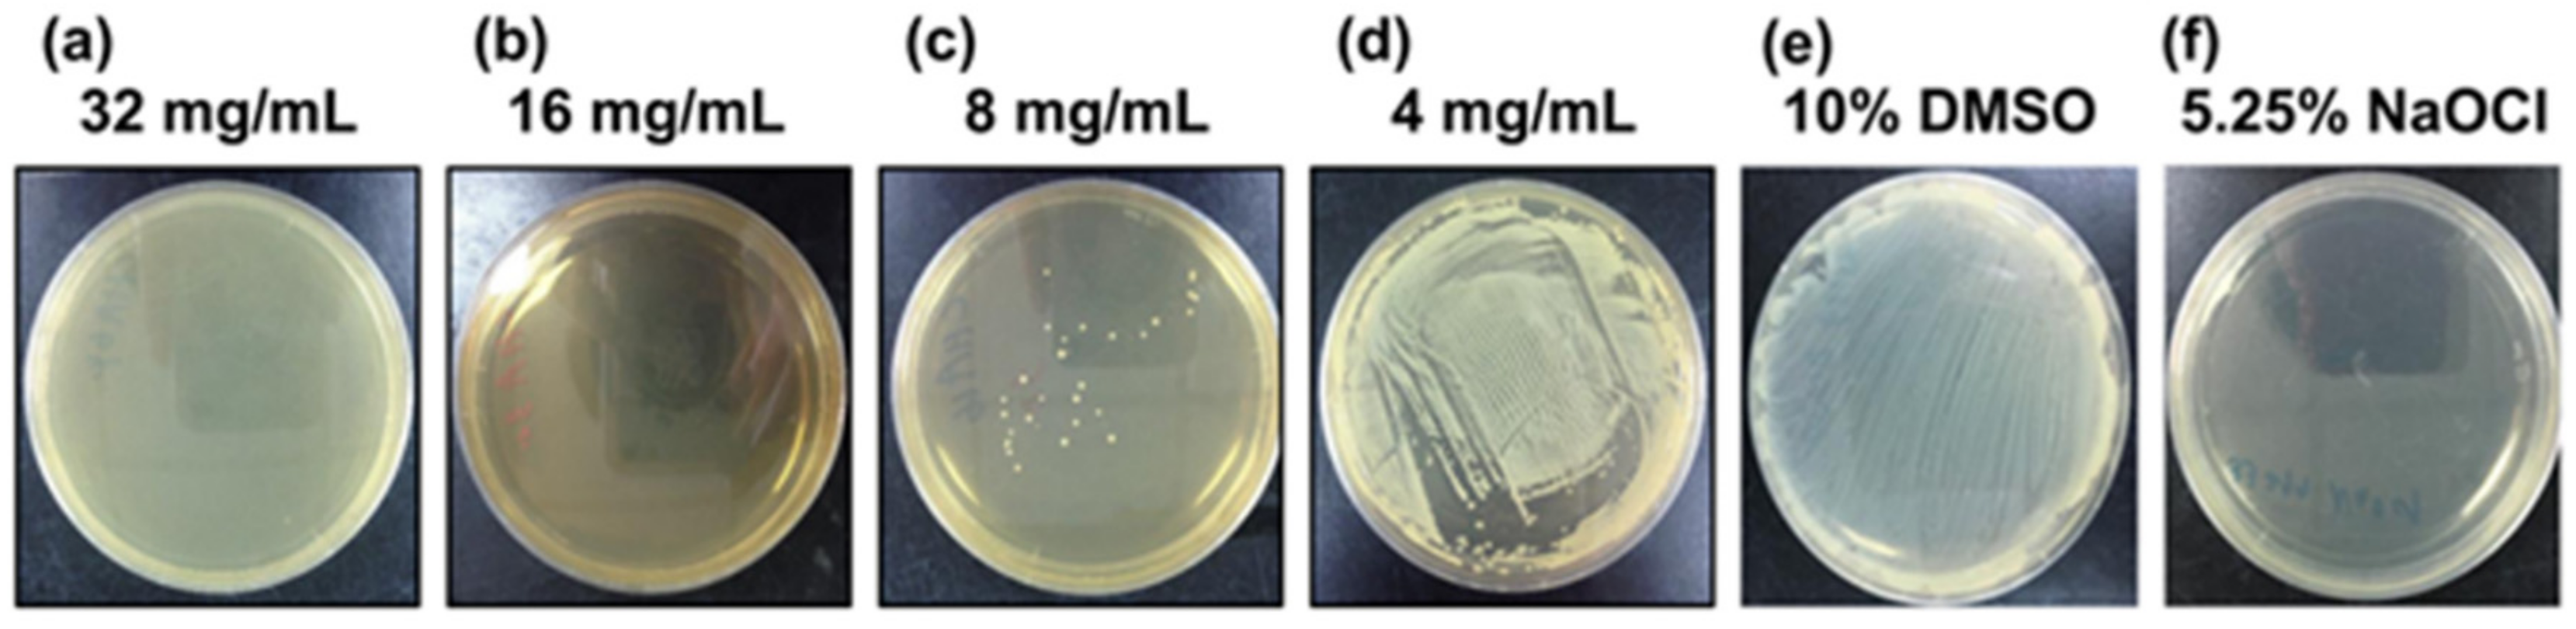
Nutrients 11 02235 g002 Nutrients 11 02235 g002

Potential Oral Health Care Agent from Coffee against Virulence Factor of Periodontitis
Abstract
1. Introduction
2. Material and Methods
2.1. Chlorogenic acid
2.2. Bacterial Strain and Culture Conditions
2.3. Bacterial Activity Tests
2.4. The Time-Kill Test
2.5. Bacterial Protease Activity Test
2.6. Coffee Preparation
2.7. Disk Diffusion Test
2.8. Statistics
3. Results
3.1. Antibacterial Activities of Chlorogenic Acid against P. gingivalis
3.1.1. Bacterial Activity Test
3.1.2. Time Kill Test
3.1.3. BANA Test
3.2. Susceptibility of P. gingivalis to Coffee Extract
Disk Diffusion Test
4. Discussion
5. Conclusions
Author Contributions
Funding
Conflicts of Interest
References
- Petersen, P.E.; Baehni, P.C. Periodontal health and global public health. Periodontol. 2000 2012, 60, 7–14. [Google Scholar] [CrossRef] [PubMed]
- Ezzo, P.J.; Cutler, C.W. Microorganisms as risk indicators for periodontal disease. Periodontol. 2000 2003, 32, 24–35. [Google Scholar] [CrossRef] [PubMed]
- Hajishengallis, G.; Darveau, R.P.; Curtis, M.A. The keystone-pathogen hypothesis. Nat. Rev. Microbiol. 2012, 10, 717–725. [Google Scholar] [CrossRef] [PubMed]
- Cohen, J. The immunopathogenesis of sepsis. Nature 2002, 420, 885. [Google Scholar] [CrossRef] [PubMed]
- Imamura, T. The role of gingipains in the pathogenesis of periodontal disease. J. Periodontol. 2003, 74, 111–118. [Google Scholar] [CrossRef] [PubMed]
- Teeuw, W.J.; Gerdes, V.E.; Loos, B.G. Effect of periodontal treatment on glycemic control of diabetic patients: A systematic review and meta-analysis. Diabetes Care 2010, 33, 421–427. [Google Scholar] [CrossRef]
- Ide, M.; Papapanou, P.N. Epidemiology of association between maternal periodontal disease and adverse pregnancy outcomes–systematic review. J. Periodontol. 2013, 84, S181–S194. [Google Scholar] [CrossRef]
- Piscoya, M.D.B.; Ximenes, R.A.; Silva, G.M.; Jamelli, S.R.; Coutinho, S.B. Maternal periodontitis as a risk factor for prematurity. Pediatr. Int. 2012, 54, 68–75. [Google Scholar] [CrossRef]
- Humphrey, L.L.; Fu, R.; Buckley, D.I.; Freeman, M.; Helfand, M. Periodontal disease and coronary heart disease incidence: A systematic review and meta-analysis. J. Gen. Intern. Med. 2008, 23, 2079–2086. [Google Scholar] [CrossRef]
- Nazir, M.A. Prevalence of periodontal disease, its association with systemic diseases and prevention. Int. J. Health Sci. 2017, 11, 72–80. [Google Scholar]
- Joët, T.; Salmona, J.; Laffargue, A.; Descroix, F.; Dussert, S. Use of the growing environment as a source of variation to identify the quantitative trait transcripts and modules of co-expressed genes that determine chlorogenic acid accumulation. Plant Cell Environ. 2010, 33, 1220–1233. [Google Scholar] [CrossRef] [PubMed]
- Higdon, J.V.; Frei, B. Coffee and health: A review of recent human research. Crit. Rev. Food Sci. Nutr. 2006, 46, 101–123. [Google Scholar] [CrossRef] [PubMed]
- Naveed, M.; Hejazi, V.; Abbas, M.; Kamboh, A.A.; Khan, G.J.; Shumzaid, M.; Ahmad, F.; Babazadeh, D.; FangFang, X.; Modarresi-Ghazani, F. Chlorogenic acid (CGA): A pharmacological review and call for further research. Biomed. Pharmacother. 2018, 97, 67–74. [Google Scholar] [CrossRef] [PubMed]
- Bouayed, J.; Rammal, H.; Dicko, A.; Younos, C.; Soulimani, R. Chlorogenic acid, a polyphenol from Prunus domestica (Mirabelle), with coupled anxiolytic and antioxidant effects. J. Neurol. Sci. 2007, 262, 77–84. [Google Scholar] [CrossRef] [PubMed]
- Chaube, S.; Swinyard, C.A. Teratological and toxicological studies of alkaloidal and phenolic compounds from Solanum tuberosum L. Toxicol. Appl. Pharmacol. 1976, 36, 227–237. [Google Scholar] [CrossRef]
- Li, B.-Q.; Dong, X.; Yang, G.-Q.; Fang, S.-H.; Gao, J.-Y.; Zhang, J.-X.; Gu, F.-M.; Miao, X.-M.; Zhao, H. Role of chlorogenic acid in the toxicity induced by Chinese herbal injections. Drug Chem. Toxicol. 2010, 33, 415–420. [Google Scholar] [CrossRef]
- Yadav, M.; Kaushik, M.; Roshni, R.; Reddy, P.; Mehra, N.; Jain, V.; Rana, R. Effect of green coffee bean extract on Streptococcus mutans count: A randomised control trial. J. Clin. Diagn. Res. 2017, 11, ZC68. [Google Scholar] [CrossRef]
- Bharath, N.; Sowmya, N.K.; Mehta, D.S. Determination of antibacterial activity of green coffee bean extract on periodontogenic bacteria like Porphyromonas gingivalis, Prevotella intermedia, Fusobacterium nucleatum and Aggregatibacter actinomycetemcomitans: An in vitro study. Contemp. Clin. Dent. 2015, 6, 166–169. [Google Scholar] [CrossRef]
- Sachin, M.; Jiji, J.; Poonam, S.; Abhishek, S.; Sweety, S.; Pooja, B. To evaluate the antimicrobial efficacy of green coffee bean extract on periopathogens-a clinico-microbiological study. Natl. J. Integr. Res. Med. 2018, 7, 56–59. [Google Scholar]
- Determination of Chlorogenic Acid in Green Coffee Beans and Dietary Supplements Labeled Green Coffee Bean Extract Using LC-MS/MS. Available online: https://www.researchgate.net/publication/268516392 (accessed on 15 May 2019).
- Corrêa, T.A.F.; Monteiro, M.P.; Mendes, T.M.N.; De Oliveira, D.M.; Rogero, M.M.; Benites, C.I.; de Matos Vinagre, C.G.C.; Mioto, B.M.; Tarasoutchi, D.; Tuda, V.L. Medium light and medium roast paper-filtered coffee increased antioxidant capacity in healthy volunteers: Results of a randomized trial. Plant Foods Hum. Nutr. 2012, 67, 277–282. [Google Scholar] [CrossRef]
- Cheng, Y. Evaluation of natural plant powders with potential use in antimicrobial packaging applications. Master’s Thesis, Rochester Institute of Technology, Rochester, NY, USA, May 2012. [Google Scholar]
- Richa, G.; Pudakalkatti, P.S.; Joshi, V. Evaluation and comparison of the antimicrobial effect of two different mouthwashes on selected periodontal pathogens: An in vitro study. J. Curr. Res. Sci. Med. 2017, 3, 40. [Google Scholar] [CrossRef]
- Berber, V.; Gomes, B.; Sena, N.; Vianna, M.; Ferraz, C.; Zaia, A.; Souza-Filho, F. Efficacy of various concentrations of NaOCl and instrumentation techniques in reducing Enterococcus faecalis within root canals and dentinal tubules. Int. Endod. J. 2006, 39, 10–17. [Google Scholar] [CrossRef]
- Giardino, L.; Ambu, E.; Savoldi, E.; Rimondini, R.; Cassanelli, C.; Debbia, E.A. Comparative evaluation of antimicrobial efficacy of sodium hypochlorite, MTAD, and Tetraclean against Enterococcus faecalis biofilm. J. Endod. 2007, 33, 852–855. [Google Scholar] [CrossRef]
- Karunanidhi, A.; Thomas, R.; Van Belkum, A.; Neela, V. In vitro antibacterial and antibiofilm activities of chlorogenic acid against clinical isolates of Stenotrophomonas maltophilia including the trimethoprim/sulfamethoxazole resistant strain. Biomed. Res. Int. 2012, 2013, 392058. [Google Scholar] [CrossRef]
- Schmidt, E.; Bretz, W.; Hutchinson, R.; Loesche, W. Correlation of the hydrolysis of benzoyl-arginine naphthylamide (BANA) by plaque with clinical parameters and subgingival levels of spirochetes in periodontal patients. J. Dent. Res. 1988, 67, 1505–1509. [Google Scholar] [CrossRef]
- Yi, T.L.; Shah, M.; Raulji, D.; Dave, D. Comparative evaluation of antimicrobial efficacy of coffee extract and 0.2% chlorhexidine mouthwash on the periodontal pathogens Porphyromonas Gingivalis, Prevotella Intermedia, Fusobacterium Nucleatum and Aggregatibacter Actinomycetemcomitans: An in vitro study. Adv. Hum. Biol. 2016, 6, 99–103. [Google Scholar] [CrossRef]
- Hajishengallis, G.; Liang, S.; Payne, M.A.; Hashim, A.; Jotwani, R.; Eskan, M.A.; McIntosh, M.L.; Alsam, A.; Kirkwood, K.L.; Lambris, J.D. Low-abundance biofilm species orchestrates inflammatory periodontal disease through the commensal microbiota and complement. Cell Host Microbe 2011, 10, 497–506. [Google Scholar] [CrossRef]
- Clifford, M.N. Chlorogenic acids and other cinnamates–nature, occurrence and dietary burden. J. Sci. Food Agric. 1999, 79, 362–372. [Google Scholar] [CrossRef]
- Upadhyay, R.; Mohan Rao, L.J. An outlook on chlorogenic acids—occurrence, chemistry, technology, and biological activities. Crit. Rev. Food Sci. Nutr. 2013, 53, 968–984. [Google Scholar] [CrossRef]
- Liang, N.; Kitts, D.D. Role of chlorogenic acids in controlling oxidative and inflammatory stress conditions. Nutrients 2015, 8, 16–35. [Google Scholar] [CrossRef]
- Lou, Z.; Wang, H.; Zhu, S.; Ma, C.; Wang, Z. Antibacterial activity and mechanism of action of chlorogenic acid. J. Food. Sci. 2011, 76, M398–M403. [Google Scholar] [CrossRef]
- Saavedra, M.J.; Borges, A.; Dias, C.; Aires, A.; Bennett, R.N.; Rosa, E.S.; Simoes, M. Antimicrobial activity of phenolics and glucosinolate hydrolysis products and their synergy with streptomycin against pathogenic bacteria. Med. Chem. 2010, 6, 174–183. [Google Scholar] [CrossRef]
- Daglia, M.; Papetti, A.; Grisoli, P.; Aceti, C.; Spini, V.; Dacarro, C.; Gazzani, G. Isolation, identification, and quantification of roasted coffee antibacterial compounds. J. Agric. Food Chem. 2007, 55, 10208–10213. [Google Scholar] [CrossRef]
- Holt, S.C.; Kesavalu, L.; Walker, S.; Genco, C.A. Virulence factors of Porphyromonas gingivalis. Periodontol. 2000 1999, 20, 168–238. [Google Scholar] [CrossRef]
- Mysak, J.; Podzimek, S.; Sommerova, P.; Lyuya-Mi, Y.; Bartova, J.; Janatova, T.; Prochazkova, J.; Duskova, J. Porphyromonas gingivalis: Major Periodontopathic Pathogen Overview. J. Immunol. Res. 2014, 2014, 476068. [Google Scholar] [CrossRef]
- Tokuda, M.; Duncan, M.; Cho, M.; Kuramitsu, H. Role of Porphyromonas gingivalis protease activity in colonization of oral surfaces. Infect. Immun. 1996, 64, 4067–4073. [Google Scholar]
- Inaba, H.; Tagashira, M.; Kanda, T.; Ohno, T.; Kawai, S.; Amano, A. Apple-and hop-polyphenols protect periodontal ligament cells stimulated with enamel matrix derivative from Porphyromonas gingivalis. J. Periodontol. 2005, 76, 2223–2229. [Google Scholar] [CrossRef]
- Löhr, G.; Beikler, T.; Hensel, A. Inhibition of in vitro adhesion and virulence of Porphyromonas gingivalis by aqueous extract and polysaccharides from Rhododendron ferrugineum L. A new way for prophylaxis of periodontitis? Fitoterapia 2015, 107, 105–113. [Google Scholar] [CrossRef]
- Farah, A.; Monteiro, M.; Donangelo, C.M.; Lafay, S. Chlorogenic acids from green coffee extract are highly bioavailable in humans. J. Nutr. 2008, 138, 2309–2315. [Google Scholar] [CrossRef]
- Mehrotra, N.; Palle, A.R.; Gedela, R.K.; Vasudevan, S. Efficacy of Natural and Allopathic Antimicrobial Agents Incorporated onto Guided Tissue Regeneration Membrane against Periodontal Pathogens: An In vitro Study. J. Clin. Diagn. Res. 2017, 11, ZC84. [Google Scholar] [CrossRef]
- Mehta, V.V.; Rajesh, G.; Rao, A.; Shenoy, R.; BH, M.P. Antimicrobial efficacy of Punica granatum mesocarp, Nelumbo nucifera leaf, Psidium guajava leaf and Coffea Canephora extract on common oral pathogens: An in-vitro study. J. Clin. Diagn. Res. 2014, 8, ZC65. [Google Scholar]
- Le Sage, F.; Meilhac, O.; Gonthier, M.-P. Anti-inflammatory and antioxidant effects of polyphenols extracted from Antirhea borbonica medicinal plant on adipocytes exposed to Porphyromonas gingivalis and Escherichia coli lipopolysaccharides. Pharmacol. Res. 2017, 119, 303–312. [Google Scholar] [CrossRef]
- Kučera, L.; Papoušek, R.; Kurka, O.; Barták, P.; Bednář, P. Study of composition of espresso coffee prepared from various roast degrees of Coffea arabica L. coffee beans. Food Chem. 2016, 199, 727–735. [Google Scholar] [CrossRef]
- Fuller, M.; Rao, N.Z. The effect of time, roasting temperature, and grind size on caffeine and chlorogenic acid concentrations in cold brew coffee. Sci. Rep. 2017, 7, 17979. [Google Scholar] [CrossRef]
- Aguiar, F.H.B.; Pini, N.P.; Lima, D.A.N.L.; Lovadino, J.R. Effect of coffee consumption on oral health. In Coffee in Health and Disease Prevention; Preedy, V.R., Ed.; Elsevier Inc.: London, UK, 2015; pp. 517–521. [Google Scholar]
- Bachrach, G.; Altman, H.; Kolenbrander, P.E.; Chalmers, N.I.; Gabai-Gutner, M.; Mor, A.; Friedman, M.; Steinberg, D. Resistance of Porphyromonas gingivalis ATCC 33277 to direct killing by antimicrobial peptides is protease independent. Antimicrob. Agents Chemother. 2008, 52, 638–642. [Google Scholar] [CrossRef]
- Kadowaki, T.; Baba, A.; Abe, N.; Takii, R.; Hashimoto, M.; Tsukuba, T.; Okazaki, S.; Suda, Y.; Asao, T.; Yamamoto, K. Suppression of pathogenicity of Porphyromonas gingivalis by newly developed gingipain inhibitors. Mol. Pharmacol. 2004, 66, 1599–1606. [Google Scholar] [CrossRef]
- Watanabe, T.; Arai, Y.; Mitsui, Y.; Kusaura, T.; Okawa, W.; Kajihara, Y.; Saito, I. The blood pressure-lowering effect and safety of chlorogenic acid from green coffee bean extract in essential hypertension. Clin. Exp. Hypertens. 2006, 28, 439–449. [Google Scholar] [CrossRef]
- Ng, N.; Kaye, E.K.; Garcia, R.I. Coffee consumption and periodontal disease in males. J. Periodontol. 2014, 85, 1042–1049. [Google Scholar] [CrossRef]
- Geng, F.; Liu, J.; Guo, Y.; Li, C.; Wang, H.; Wang, H.; Zhao, H.; Pan, Y. Persistent Exposure to Porphyromonas gingivalis Promotes Proliferative and Invasion Capabilities, and Tumorigenic Properties of Human Immortalized Oral Epithelial Cells. Front. Cell. Infect. Microbiol. 2017, 7. [Google Scholar] [CrossRef]
- Yuan, X.; Liu, Y.; Kong, J.; Gu, B.; Qi, Y.; Wang, X.; Sun, M.; Chen, P.; Sun, W.; Wang, H. Different frequencies of Porphyromonas gingivalis infection in cancers of the upper digestive tract. Cancer Lett. 2017, 404, 1–7. [Google Scholar] [CrossRef]
- Park, D.-G.; Woo, B.H.; Lee, B.-J.; Yoon, S.; Cho, Y.; Kim, Y.-D.; Park, H.R.; Song, J.M. Serum Levels of Interleukin-6 and Titers of Antibodies against Porphyromonas gingivalis Could Be Potential Biomarkers for the Diagnosis of Oral Squamous Cell Carcinoma. Int. J. Mol. Sci. 2019, 20, 2749. [Google Scholar] [CrossRef]
- Mascitti, M.; Togni, L.; Troiano, G.; Caponio, V.C.A.; Gissi, D.B.; Montebugnoli, L.; Procaccini, M.; Lo Muzio, L.; Santarelli, A. Beyond Head and Neck Cancer: The Relationship Between Oral Microbiota and Tumour Development in Distant Organs. Front. Cell. Infect. Microbiol. 2019, 9. [Google Scholar] [CrossRef]
- Woo, B.H.; Da Jeong Kim, J.I.C.; Kim, S.J.; Park, B.S.; Song, J.M.; Lee, J.H.; Park, H.R. Oral cancer cells sustainedly infected with Porphyromonas gingivalis exhibit resistance to Taxol and have higher metastatic potential. Oncotarget 2017, 8, 46981. [Google Scholar] [CrossRef]
- Huang, R.; Li, M.; Gregory, R.L. Bacterial interactions in dental biofilm. Virulence 2011, 2, 435–444. [Google Scholar] [CrossRef]

| Coffee Concentration (g/mL) | Light Roast | Dark Roast | Distilled Water † | ||||||
|---|---|---|---|---|---|---|---|---|---|
| 0.03 | 0.07 | 0.17 | 0.33 | 0.03 | 0.07 | 0.17 | 0.33 | ||
| Diameter mean (SD) (mm) | 0 (0) | 8.4 (0.5) | 10.6 (0.5) | 12.8 (0.8) | 0 (0) | 7.9 (0.8) | 10.3 (0.7) | 12.5 (0.8) | 0 (0) |
© 2019 by the authors. Licensee MDPI, Basel, Switzerland. This article is an open access article distributed under the terms and conditions of the Creative Commons Attribution (CC BY) license (http://creativecommons.org/licenses/by/4.0/).
Share and Cite
Tsou, S.-H.; Hu, S.-W.; Yang, J.-J.; Yan, M.; Lin, Y.-Y. Potential Oral Health Care Agent from Coffee against Virulence Factor of Periodontitis. Nutrients 2019, 11, 2235. https://doi.org/10.3390/nu11092235
Tsou S-H, Hu S-W, Yang J-J, Yan M, Lin Y-Y. Potential Oral Health Care Agent from Coffee against Virulence Factor of Periodontitis. Nutrients. 2019; 11(9):2235. https://doi.org/10.3390/nu11092235
Chicago/Turabian StyleTsou, Sing-Hua, Suh-Woan Hu, Jaw-Ji Yang, Min Yan, and Yuh-Yih Lin. 2019. "Potential Oral Health Care Agent from Coffee against Virulence Factor of Periodontitis" Nutrients 11, no. 9: 2235. https://doi.org/10.3390/nu11092235
APA StyleTsou, S.-H., Hu, S.-W., Yang, J.-J., Yan, M., & Lin, Y.-Y. (2019). Potential Oral Health Care Agent from Coffee against Virulence Factor of Periodontitis. Nutrients, 11(9), 2235. https://doi.org/10.3390/nu11092235






